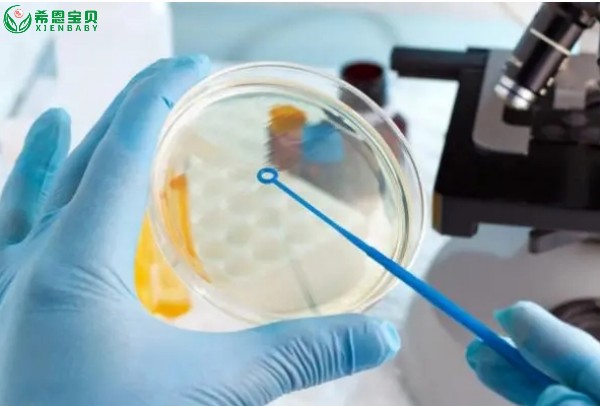

绝经是指女性卵巢功能衰退,月经停止的生理现象。在自然状态下,女性的生育能力随着年龄的增长而逐渐下降,而绝经则标志着女性生育能力的完全丧失。然而,近年来随着生殖医学技术的不断发展,一些女性在绝经...
绝经是指女性卵巢功能衰退,月经停止的生理现象。在自然状态下,女性的生育能力随着年龄的增长而逐渐下降,而绝经则标志着女性生育能力的完全丧失。然而,近年来随着生殖医学技术的不断发展,一些女性在绝经后仍希望通过试管婴儿技术实现生育梦想。那么,绝经一年的女性还能通过调理顺利取卵做试管婴儿吗?
一、女性生育能力的变化
女性的生育能力随着年龄的增长而逐渐下降,这是由于卵巢功能衰退所引起的。在青春期,卵巢开始产生卵子,并逐渐发育成熟。随着年龄的增长,卵巢功能逐渐衰退,卵子的数量和质量也逐渐下降。当女性进入更年期后,卵巢功能逐渐衰退至完全丧失,月经停止,生育能力也随之消失。
二、绝经后卵巢功能的恢复
虽然绝经标志着女性生育能力的完全丧失,但是一些女性在绝经后仍希望通过调理恢复卵巢功能,取卵进行试管婴儿技术。然而,卵巢功能的恢复并不是一件容易的事情。首先,卵巢功能衰退是一个不可逆的过程,卵巢中的卵子数量和质量会随着年龄的增长而逐渐下降。其次,女性的生育能力受到多种因素的影响,如遗传、环境、生活方式等。因此,即使进行调理,也难以保证卵巢功能能够完全恢复。
三、绝经后试管婴儿技术的可行性
尽管一些女性希望通过调理和试管婴儿技术实现生育梦想,但是绝经后进行试管婴儿技术的可行性存在一定的争议。一方面,一些研究表明,绝经后女性进行试管婴儿技术的成功率较低,因为卵巢中的卵子数量和质量已经下降到了较低的水平。另一方面,一些医生认为,如果绝经后女性在接受调理后能够恢复卵巢功能,那么进行试管婴儿技术是有可能的。
四、如何提高成功率
对于绝经后女性来说,如果仍希望通过试管婴儿技术实现生育梦想,可以尝试以下方法来提高成功率:
1. 接受全面的身体检查:全面了解自己的生育能力和身体健康状况,以便更好地制定调理和试管婴儿计划。
2. 接受专业的调理:在医生的指导下进行调理,包括饮食、运动、药物治疗等,以恢复卵巢功能和提高生育能力。
3. 选择合适的试管婴儿技术:根据自身情况选择合适的试管婴儿技术,如体外受精、卵子捐赠等。
4. 积极配合医生的治疗:在治疗过程中保持积极配合的态度,遵循医生的建议和指导,以提高成功率。

五、结论
虽然绝经后女性仍有一定的生育可能性,但是成功率较低。在进行相关治疗前需要充分了解自己的生育能力和健康状况,并在医生的指导下进行调理和治疗。同时,也要认识到生育能力的下降是一个不可逆的过程,尽早采取措施保护自己的生育健康是非常重要的。
除了以上提到的几点,还有一些额外的建议可以帮助绝经后女性提高试管婴儿的成功率。
首先,保持良好的生活习惯和心态非常重要。合理安排饮食,保证营养均衡,同时适当运动,增强体质。此外,避免过度压力和焦虑,保持乐观的心态,也有助于提高成功率。
其次,选择专业、技术先进的生殖医学中心进行治疗也是关键。了解中心的资质、技术水平和医生经验,选择适合自己的医生和中心进行治疗。在治疗过程中,与医生保持良好沟通,充分了解治疗方案和风险,积极配合医生的治疗和建议。
最后,虽然绝经后女性生育的可能性较低,但是通过调理和试管婴儿技术仍有一定的可能性实现生育梦想。了解自己的生育能力和健康状况,采取合适的措施,保持积极的心态,是提高成功率的关键。
希恩宝贝是专业协助不孕不育夫妻到海外医疗就诊的辅助生殖服务机构,9年来帮助了上千个家庭实现了生儿育女的梦想。哈萨克斯坦希恩宝贝圆梦地接,具体服务内容添加壹伍叁贰壹叁零玖伍壹捌微信同号,免费领取助孕大礼包!包括前期咨询、海外接待食宿行、对接海外权威主治医生、专业医疗翻译陪同就诊,爱心志愿者的筛选、匹配和支持、以及小孩出生后协助办理回国证件等全程一站式服务。让您海外试管助孕无忧。搜索希恩宝贝,更多惊喜等着您,助您早日生子!